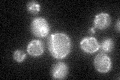
YIR021W
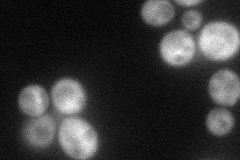
YIR021W
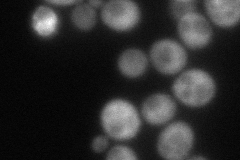
YIR021W

View description
Protein required for the splicing of two mitochondrial group I introns (BI3 in COB and AI5beta in COX1); forms a splicing complex, containing four subunits of Mrs1p and two subunits of the BI3-encoded maturase, that binds to the BI3 RNA
Localization:
Intensity:
Fold change:
Significance:
-
C’ GFP library in SD
mitochondria25.82 -
N' NOP1pr-GFP in SD
cytosol64.0775 -
N' TEF2pr-mCherry in SD
cytosol78.0228 -
N' NATIVEpr-GFP in SD

missing0 -
N' TEF2pr-VC and Cyto-VN in SD

#N/A0 -
C’ GFP library in SD+DTT

mitochondriaN/AN/ANo -
C’ GFP library in SD+H2O2

mitochondria19.030.73Yes -
C’ GFP library in Starvation Media

mitochondria33.771.3No -
C’ GFP library on the background of Pup2-DaMP

mitochondria -
C’ GFP library on the background of CCT mutant

mitochondria24.94310.965745No
